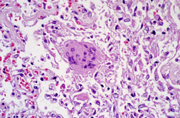

Американские ученые из Национального института аллергологии и инфекционных заболеваний сообщили об успешном завершении работ по созданию вакцины против атипичной пневмонии (SARS). Сейчас разработанный ими препарат готовится к клиническим испытаниям.
Разработанная учеными вакцина представляет собой суспензию фрагментов вируса атипичной пневмонии. В отличие от аналогичных препаратов, она вводится не внутривенно или внутримышечно, а назально, в виде специального спрея. Соответственно, вакцина оказывает максимальный эффект в дыхательных путях, являющихся «входными воротами» для SARS, и практически не действует на уровне всего организма.
KM.RU: Здоровье